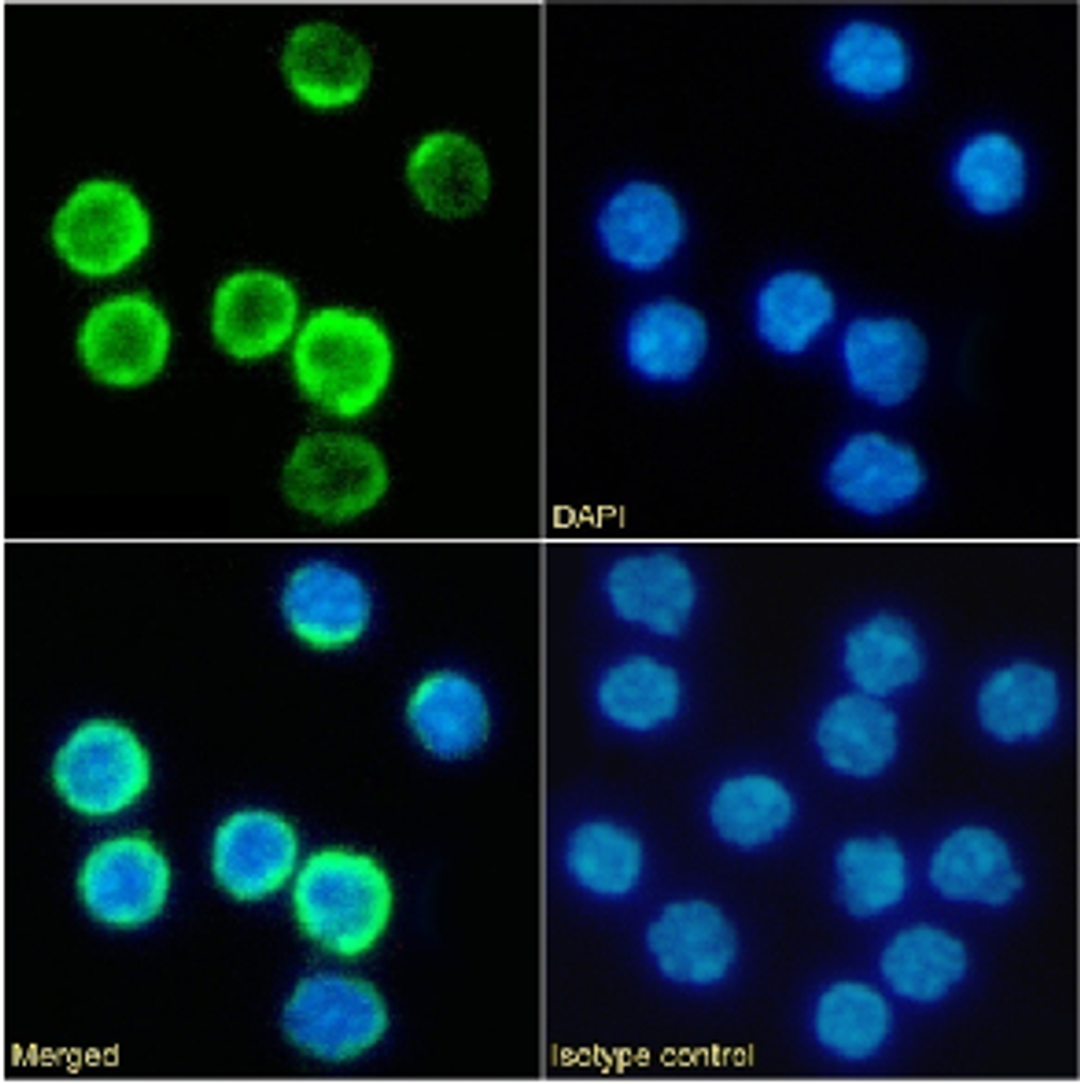
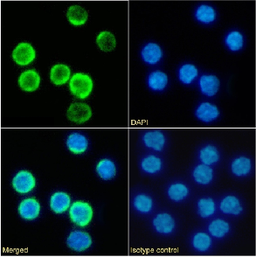

Product & ReviewsAntibodies
CD25 Antibody [PC-61.5.3], Rabbit IgG
Product Details
- Cat. No.
- 24-631
- Type
- Primary Antibody
- Clonality
- Recombinant
- Host
- Human

The supplier does not provide quotations for this antibody through SelectScience. You can search for similar antibodies in our Antibody Directory.
Biological Information
- Clonality: Recombinant
- Host: Human
- Conjugate: Unconjugated
Handling
- Quantity: 0.2 mg
- Storage: Store at 4⁰C for up to 3 months. For longer storage, aliquot and store at -20⁰C.
- Buffer: PBS with 0.02% Proclin 300.